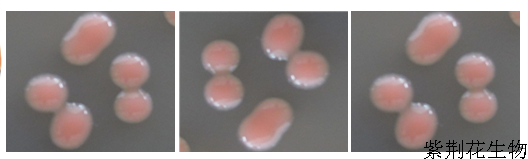

1产品特性
海洋红酵母是从海泥中分离出来的单细胞真核生物,富含多种活性物质,适宜生长温度4-27℃,海洋红酵母具有适口性好,营养全面,无毒,不污染水质的特性

主要成分
1、虾青素等 虾青素不能自身合成
2、脂肪 脂肪含量4.09%,富含EPA、DHA等不饱和脂肪酸
3、总糖 总糖含量29.5%,主要以甘露聚糖和葡聚糖为主的酵母多糖
4、蛋白质 粗蛋白含量48.01%,传统面包酵母29%
功效一:营养功能
高蛋白
为水产养殖生物提供丰富的营养来源,保证水产动物对营养的需求
赖氨酸
高含量的赖氨酸弥补动物对赖氨酸需求的不足
必需氨基酸
提供生物必需的10种必需氨基酸,且含量高
功效二:免疫功能

使用效果




